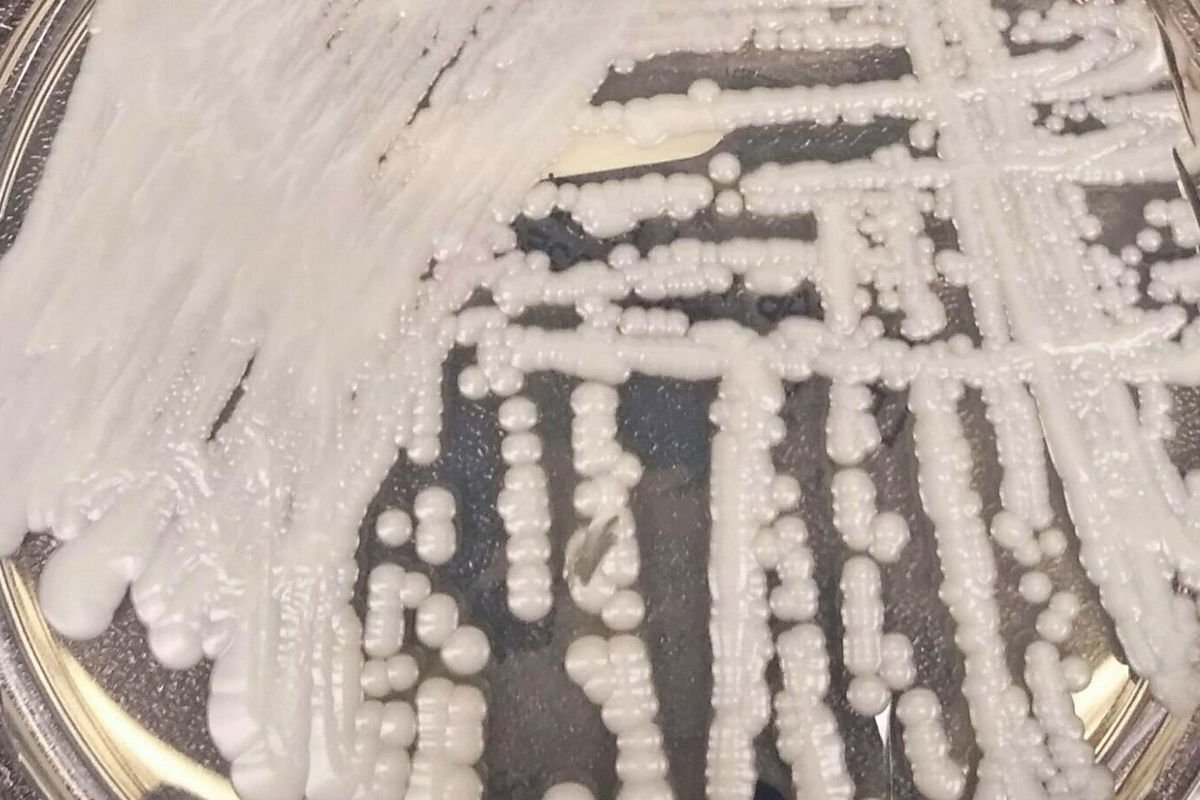
Cientistas registram maior surto do fungo Candida auris no Brasil

Cientistas registram maior surto do fungo Candida auris no Brasil
Em um hospital de Recife (PE), foram verificados 48 casos, entre novembro de 2021 e fevereiro de 2022
Foto: Reprodução/Agência Brasil
Cientistas da Fundação Oswaldo Cruz (Fiocruz) identificaram o terceiro e maior surto causado pelo fungo Candida auris no Brasil. O resultado é consequência dos 48 casos confirmados em um hospital de Recife, em Pernambuco, entre novembro de 2021 e fevereiro de 2022. Os dados serão publicados na revista científica Frontiers in Cellular and Infection Microbiology.
O fungo, nomeado de C. auris, representa uma séria ameaça à saúde pública, já que o microrganismo possui a capacidade de resistir aos principais medicamentos antifúngicos.
De acordo com o coordenador da pesquisa, Manoel Marques Evangelista Oliveira, do Laboratório de Taxonomia, Bioquímica e Bioprospecção de Fungos do Instituto Oswaldo Cruz (IOC/Fiocruz), o diagnóstico da infecção é um dos principais objetivos da pesquisa de fungos no país.
“O grande foco na pesquisa científica de fungos no Brasil hoje é termos a resposta para os casos suspeitos de infecções fúngicas para ajudar os pacientes”, afirma.
Os pesquisadores destacam ainda que a disponibilização de metodologias rápidas e com identificação precisa é essencial para a implementação de medidas adequadas de prevenção e controle do fungo.


